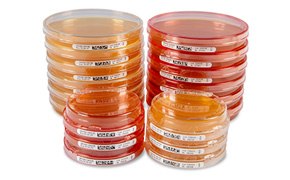
A close-up view of multiple petri dishes in various sizes, some stacked and others placed separately, all labeled, demonstrating a variety of cultured media in a laboratory setting.

IsoBag® Rapid Transfer Solution Optimizes Your Environmental Monitoring Workflow
The safe transfer of materials into controlled areas, such as cleanrooms and isolators, presents significant challenges. Recent updates to regulations like the EU GMP Annex 1, emphasizing stringent control of this process, made this even more apparent. As environmental monitoring becomes increasingly complex, effective management of risks associated with material transfers is essential.
IsoBag® Rapid Transfer Solution provides a solution by enabling the safe and efficient transfer of contact and settle plates directly into isolators without the need for prior decontamination.

This approach ensures safe material transfer, reduces cross-contamination risk, and extends the operation time between decontamination cycles, leading to fewer contamination cycles.
Utilizing the DPTE® - Rapid Transfer Technology, plates inside the IsoBag® remain readily accessible to your processes inside the isolator at all times. That allows you to optimize your workflow and ensure compliance with regulatory standards while minimizing contamination risks.
Comparison of environmental monitoring workflow in an aseptic production with and without IsoBag® rapid transfer solution
Experience the difference in efficiency, safety, and cost-effectiveness when using IsoBag® Rapid Transfer Solution in your aseptic production workflow.


Unique Features of IsoBag® rapid transfer solution
- Pre-packed DPTE BetaBag®: Ready-to-use, single-bagged contact or settle plates for immediate application.
- Beta Port Compatibility: Connects to any 190 mm DPTE® Alpha port for versatile use.
- Media Options: Available with several TSA + neutralizer combinations in lockable and non-lockable contact and settle plates.
- Traceable Plates: Includes single-lot ICR plates, seamlessly traceable by their individual data matrix code
- Multiple Connections: Facilitates efficient operation with multiple connections.
- Sterile Transport Bags: Ensures safe transport of used plates while maintaining sterility.
- Safe Material Transfer: Enhances secure handling of materials, reducing contamination risks.
- Reduced Cross-Contamination Risk: Minimizes potential contamination between samples.
- Extended Operation Time: Increases the time between decontamination cycles using IsoBag®, leading to fewer contamination cycles overall.
ICR/ICR Plus Contact and Settle Plates Available in IsoBag® Rapid Transfer Solution
We offer a comprehensive range of plates specifically designed for environmental monitoring in isolators and critical cleanrooms, including the Contact Plates and Settle Plates, ensuring maximum safety, reliability, and convenience.
ICR Contact and Settle Plates Ensure Maximum Safety, Reliability, and Convenience
- Data matrix barcode on each plate
- Transparent, VHP-impermeable, barrier packaging
- Produced in aseptic environments and irradiated in the final packaging
- Prepared according to EP/USP recommendations
- Flexible storage between 2-25°C
- Up to 12 months shelf life
- Available with up to four neutralizers for the inactivation of a wide range of disinfectants and inhibiting VHP residues
- The contact and settle plates of our ICRplus range additionally feature CLOSED and VENT closure options for safe transportation and variable incubation conditions
Related Products
To continue reading please sign in or create an account.
Don't Have An Account?